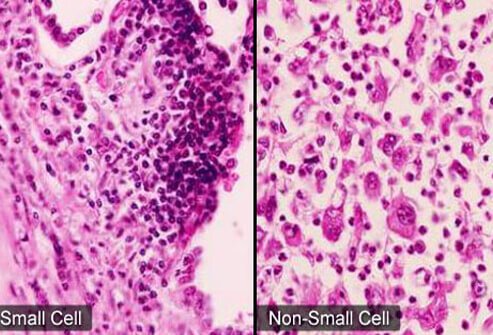
小细胞肺癌

小细胞癌

小细胞癌朋友们帮忙看看这是转移没有啊
图片尺寸1560x2080
病理图片(小细胞癌)
图片尺寸1080x810
病理:小细胞肺癌.明确了诊断,也明确了临床分期.
图片尺寸1440x1080
肺小细胞癌的形态与研究现状
图片尺寸640x480
左侧鼻腔神经内分泌型小细胞癌
图片尺寸1792x1344
膀胱小细胞癌病理图谱
图片尺寸661x496
右卵巢小细胞癌2016.9.18【91360妇科病理沙龙病例108】
图片尺寸1280x960
三例小细胞肺癌的病理解读
图片尺寸750x563
【图】小细胞癌详细图解(唾液腺恶性肿瘤的临床病理)
图片尺寸671x638
美轮美奂的胸水小细胞癌
图片尺寸720x1098
癌:尼妥珠单抗;黑色素瘤:威罗非尼,曲美替尼,达拉非尼;室管膜下巨细胞
图片尺寸989x746
小细胞鳞状细胞癌
图片尺寸504x374
小细胞肺癌是怎么发生的为何只有5能早期手术
图片尺寸640x366
小细胞肺癌
图片尺寸493x335
肺癌 19缺失突变 自愈_kras突变 肺癌_肺癌突变吃吉非替尼
图片尺寸1395x1054
宫颈神经内分泌肿瘤-小细胞癌讨论病例【中美加病理学交流群病例27】
图片尺寸1280x1280
肺小细胞癌
图片尺寸300x300
肺小细胞癌(黄勇)
图片尺寸1233x996
膀胱小细胞癌病理图谱
图片尺寸661x496
左侧鼻腔神经内分泌型小细胞癌
图片尺寸1792x1344